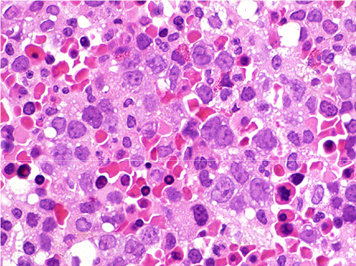

第24回
22.NUTRITIONAL DEFICIENCIES栄養欠乏症(ビタミン欠乏症)(一部筆者追加)
[重要用語]
a.
Lipid Soluble脂溶性ビタミン欠乏症
1.Vitamin A
・night blindness夜盲症
・dry eyes眼球乾燥症(xerophthalmia) and dry skin乾燥皮膚
・recurrent infections易感染症
*:粘液分泌上皮の扁平上皮化生squamous metaplasiaが角膜,結膜,上気道,泌尿器系,膵臓,唾液腺等でみられることが上記の原因と考えられる.
2.Vitamin D
・decreased calciumカルシウム減少
・bone --> decreased calcification石灰化減少,
increased osteoid類骨増加
・children --> riketsくる病
・adult --> osteomalacia骨軟化症
*:不十分な石灰化が起こり,そのために類骨基質が不規則に増え,骨格の変形を来すと考えられています.
3.Vitamin
E
・degeneration of posterior columns of spinal cord脊髄後索の変性
脊髄小脳変性症,骨格筋の異常,小児の溶血性貧血
4.Vitamin
K
・decreased vitamin K-dependent factors --> II, VII, IX, X, and
proteins C and S
(ビタミンK依存性で肝臓で新生される)
・increased bleeding出血増加
・increased PTプロトロンビン時間 and PTT部分トロンボプラスチン時間の増加
b. Water Soluble水溶性ビタミン欠乏症
1.Vitamin B1 (thiamine)チアミン
・beriberi脚気 --> wet (cardiac) or dry
(neurologic)
wet beriberi:心臓が弛緩性に拡張し,心室壁は菲薄化.心筋細胞の変性や間質に浮腫.心拍出量減少,末梢の浮腫.
Dry beriberi:下肢の運動,感覚障害(両側性多発性ニューロパチー)進行すると上肢,胴体に及ぶ.感覚麻痺,筋力低下,反射消失.
・Wernicke-Korsakoff syndrome (lesions of mamillary bodies乳頭体や視床,視床下部,中脳水道などに出血,壊死巣) 眼筋麻痺,眼振,下肢運動失調,記憶障害,作話.
2.Vitamin B3 (niasin)ナイアシン
・pellagraペラグラ -->3Ds:dermatitis皮膚炎, dementia痴呆, diarrhea下痢 (and death)
3.Vitamin B12
(cobalamin)シアノコバラミン
・megaloblastic (macrocytic) anemia巨赤芽球性貧血
・hypersegmented neutrophils (> 5 lobes)好中球の過分葉
・subacute combined degeneration of the spinal cord脊髄伝導路の変性
4.Vitamin C (ascorbic
acid)アスコルビン酸
・scurvy壊血病
・defective collagen formation コラーゲン形成障害-->
poor wound healing (wounds reopen)創傷治癒障害
・bone --> decreased osteoid類骨基質の形成異常
・perifollicular hemorrhages毛包周囲性(点状)出血
("corkscrew" hair捻転毛)
・bleeding gums歯肉出血 and loose teeth緩い歯
5.Folate葉酸
・megaloblastic (macrocytic) anemia巨赤芽球性貧血
・hypersegmented neutrophils好中球の過分葉
・associated with neural tube defects in utero妊娠初期では神経管閉鎖障害と関連.
無脳児の発生リスクが上昇.
6.Iron 鉄---> microcytic
hypochromic anemia小球性低色素性貧血(with increased TIBC総鉄結合能の増加を伴う)
[解説および参考資料]
Vitamin
A,D,E,Kは脂溶性,VitaminC、B複合体は水溶性です.脂溶性ビタミンは体内に貯蔵され,長期にわたって欠乏した際に利用されます.水溶性ビタミンは貯蔵量は少なく,そのため短期間の摂取不足でも欠乏状態になります.ビタミンD,K,B複合体のナイアシン,ビオチンは少量ではありますが体内で合成されます.ビタミン欠乏症は1)食事に起因するもの,と2)吸収,輸送,貯蔵,代謝などの異常によるものがあります.ビタミンA, D欠乏症が最も多くみられます.
・ビタミンA:粘膜上皮の機能維持,免疫能の増強,抗オキシダント機能,抗癌原性作用などがあり,網膜色素の構成成分です.黄色・緑色野菜に含まれ,消化吸収には胆汁酸,膵酵素が必要.吸収後肝臓で貯蔵されます.
・ビタミンD:機能は,骨の生理的な石灰化に必要となるカルシウムとリンの血中レベルを維持することにあります.皮膚で紫外線により形成されるD3と乳製品などの食事性のD2とがあります.血中に移行したビタミンDは結合タンパクと結合して肝臓に輸送され,肝,腎で変換後に活性型ビタミンDになります.
・ビタミンE:トコフェロールともよばれ,D-αトコフェロールは自然界に広く普遍的に存在するとされます.いずれも抗オキシダント効果を有しており,代謝によって生じるフリーラジカルから細胞を守る働きをもっており,フリーラジカルによる脂質の連鎖的酸化を阻止すると考えられています.これにより生じたビタミンEラジカルはビタミンCなどの抗酸化物質によって再生します.
・ビタミンK:胆汁酸や膵液と混合され小腸から吸収され肝臓に運ばれ肝臓で合成される、骨の石灰化調節因子となるタンパク質や血液凝固に必要なタンパク性の凝固因子に関与している。生体内では血液凝固作用,骨へのカルシウム定着作用がある.
・ビタミンB1:多くの食物に含まれる.吸収時にリン酸化を受け活性型となる.酸化的脱炭酸化反応によるATPの合成,リン酸化五単糖の代謝過程,末梢神経の細胞膜や神経伝導の維持などに関連します.
・ビタミンB3:種々の脱水素反応に関与しています.
・ビタミンB12:シアノコバラミンは化合物を単離する際に得られる人工産物で、喫煙者などの特殊な場合を除き、体内ではシアノコバラミンは存在していないと考えるのが普通になっている。ポルフィリン類似のコリン環とヌクレオチドの構造をもつ、コバルトの錯体である。アミノ酸や脂肪酸の代謝および葉酸の生合成に用いられる。
・ビタミンC:体内では合成されない.すべて食事に由来します.吸収量には限界があり大量摂取しても効果は少ないといわれます.プロリン・リジン水酸化酵素を活性化する機能を持っています.プロコラーゲンの水酸化を誘導し線維芽細胞からのコラーゲン産生を増強します.
・葉酸:葉酸はアミノ酸や核酸の合成に必要となる補酵素であるため、細胞分裂の盛んな箇所において欠乏症が現れやすいとされています。症状は、貧血、免疫機能減衰、消化管機能異常などが見られます.
・鉄:吸収は上部小腸で行われます.還元型のFe2+で吸収されやすいが,食物中は大部分が参加型のFe3+です.腸上皮細胞微絨毛膜に存在するFe3+還元酵素によってFe2+になり刷子縁膜にある鉄チランスポーターから取り込まれます.
[参考]病態病理学(改訂17版)
wikipedia
[参考画像]
a.
b. 
a.b:好中球の過剰分葉(a:パパニコロウ染色, b.ギムザ染色).ビタミンB12や葉酸欠乏で認められる.
[演習問題]
図は巨赤芽球性貧血の骨髄組織である.原因について正しいのはどれか.
日本病理学会「病理コア画像」よりhttp://jsp.umin.ac.jp/corepictures2010/01/c02/01.html
a.鉄欠乏
b.ビタミンA欠乏
c.ビタミンC欠乏
d.ビタミンB6欠乏
e.ビタミンB12欠乏
f.ビタミンD欠乏
g.ビタミンK欠乏
h.葉酸欠乏
正解:e.h